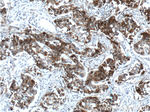
p120 Catenin Antibody in Immunohistochemistry (Paraffin) (IHC (P))
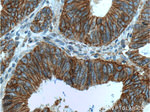
p120 Catenin Antibody in Immunohistochemistry (Paraffin) (IHC (P))
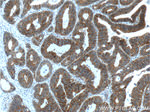
p120 Catenin Antibody in Immunohistochemistry (Paraffin) (IHC (P))

Search
Proteintech
p120 Catenin Monoclonal Antibody (2F7H8)
{{$productOrderCtrl.translations['antibody.pdp.commerceCard.promotion.promotions']}}
{{$productOrderCtrl.translations['antibody.pdp.commerceCard.promotion.viewpromo']}}
{{$productOrderCtrl.translations['antibody.pdp.commerceCard.promotion.promocode']}}: {{promo.promoCode}} {{promo.promoTitle}} {{promo.promoDescription}}. {{$productOrderCtrl.translations['antibody.pdp.commerceCard.promotion.learnmore']}}
产品信息
66208-1-IG
种属反应
已发表种属
宿主/亚型
分类
类型
克隆号
抗原
偶联物
形式
浓度
纯化类型
保存液
内含物
保存条件
运输条件
产品详细信息
Immunogen sequence: GYELLFQPE VVRIYISLLK ESKTPAILEA SAGAIQNLCA GRWTYGRYIR SALRQEKALS AIADLLTNEH ERVVKAASGA LRNLAVDARN KELIGKHAIP NLVKNLPGGQ QNSSWNFSED TVISILNTIN EVIAENLEAA KKLRETQGIE KLVLINKSGN RSEKEVRAAA LVLQTIWGYK ELRKPLEKEG WKKSDFQVNL NNASRSQSSH SYDDSTLPLI DRNQKSDKKP DREEIQMSNM GSNTKSLDNN YSTPNERGDH NKTLDRSGDL GDMEPLKGTT PLMQKI (546-830 aa encoded by BC010501)
靶标信息
Delta 1 Catenin is an efficient tyrosine kinase substrate implicated both in cell transformation by SRC and in ligand-induced receptor signaling through the EGF, PDGF, CSF-1 and ERBB2 receptors. The association of catenins to cadherins produces a complex which is linked to the actin filament network, and which seems to be of primary importance for cadherins cell-adhesion properties.
仅用于科研。不用于诊断过程。未经明确授权不得转售。
生物信息学
蛋白别名: Cadherin-associated Src substrate; Cadherin-associated Src substrate (CAS); CAS; Catenin (cadherin associated protein) delta 1; catenin (cadherin-associated protein), delta 1; Catenin delta-1; catenin src; p120 catenin; P120 CTN; P120 p120; P120 P120CTN; p120(cas); p120(ctn); p120-catenin
基因别名: AA409437; AU019353; CAS; Catns; CTNND; CTNND1; KIAA0384; mKIAA0384; P120; p120(CAS); p120(CTN); P120CAS; P120CTN
UniProt ID: (Human) O60716, (Mouse) P30999
Entrez Gene ID: (Human) 1500, (Mouse) 12388, (Rat) 311163